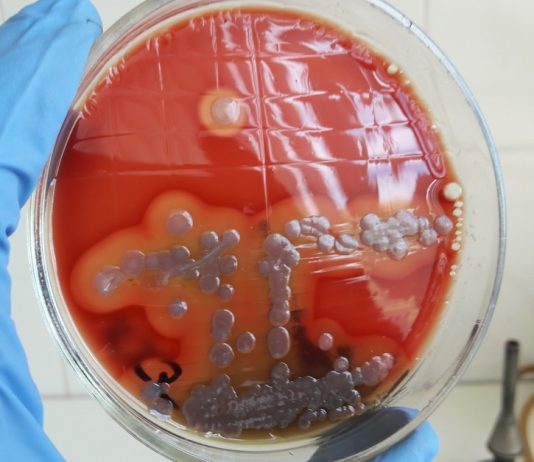
Какие инфекции показывает бак посев

В мире, невидимом для невооруженного глаза, развертывается настоящая драма в микроскопических масштабах, где героями являются бактерии. И чтобы раскрыть этот биологический триллер, на помощь приходит метод – бак посев.
Путешествие в мир бактерий
Бактерии – разнообразные микроорганизмы, обитающие повсюду, от наших кожных покровов до далеких уголков природы. Некоторые из них –...
Опухание руки является распространенным симптомом, возникающим по разным причинам. Это явление может быть вызвано как нарушениями в организме, так и механическими повреждениями. Опухание руки может быть временным и проходить самостоятельно через некоторое время, однако в некоторых случаях оно может свидетельствовать о серьезных заболеваниях.
Одной из наиболее распространенных причин почему опухает...
ЭТО ВАМ ПРИГОДИТСЯ
Что такое криолиполиз: показания и противопоказания
Крио-липосакция - методика удаления жировых отложений с помощью холода. Процедура не требует сложной подготовки и длительного реабилитационного периода.
Для проведения процедуры используется специальный аппарат, которым...
Нужна ли справка в спортзал?
Сегодня вы найдете фитнес-центр в относительно небольшом городке, который не превышает нескольких тысяч жителей. Тренажерные залы давно стали повседневностью. График работы установлен с раннего...
Термоподносы от компании EQ-VIP и их особенности
В рамках инновационной технологии раздачи готовых блюд пациентам больниц, термоподносы посмотреть является наиболее эффективным и удобным решением. Термоподносы EQ-VIP специально разработаны для обеспечения сохранности...
Классификаторы и справочники по болезням: в чем плюсы
Условием эффективности работы системы здравоохранения является достоверность учета количества заболеваний по отдельным категориям, анализ данных учета.
В этом помогает использование специально разработанных справочников и классификаторов...
Препараты при эпилепсии: что важно знать?
Лечение эпилепсии требует постоянного контроля за состоянием здоровья пациента и приема назначенных врачом препаратов.
Это, прежде всего противоэпилептические средства, позволяющие контролировать появление приступов и снижать...
Особенности и виды перманентного макияжа
На сегодняшний день перманентный макияж уже не является редкостью, а представляет собой, скорее, вполне распространенное явление. Популярность перманентного макияжа вполне объяснима: такой вариант удобен,...
Как же хочется прогуляться по весеннему цветущему лугу, насладиться свежим, у вас на глазах выкачанным из улья медом, поиграть с пушистым домашним любимцем… но… Вы можете делать все это только в мечтах из-за упорной и мучительной аллергии?